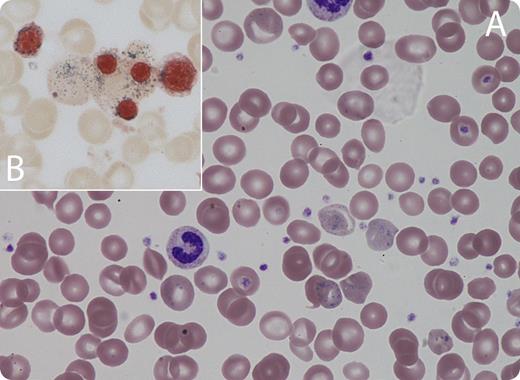
A 63-year-old man presented with symptoms of anemia. The only other symptom of note was some change in personality with unusually aggressive behavior. His blood count was as follows: hemoglobin 65 g/L, white blood cell count 6.5 × 109/L (normal differential count), and platelet count 509 × 109/L. The blood film (panel A) was leukoerythroblastic with target cells and marked basophilic stippling. Liver function test results and hematinics were normal. / On retaking the clinical history, it was noted that he was a painter and had been working on an old house for several months, removing paint. His blood lead level was 4.9 μmL/L (reference range without exposure to industrial lead is 0-0.48 μmL/L) with a high 24-hour urinary lead level of 2130 nmol (normal range, 0-100). These results were consistent with severe lead poisoning. He was treated with chelation with intravenous sodium calcium edetate, intravenous fluids, and zinc supplementation. He obtained gradual improvement in psychiatric symptoms and normalization of blood count. He did not have the usual classical symptoms of lead poisoning. His bone marrow aspirate and trephine morphology showed marked dyserythropoiesis with sideroblastic change and also less marked dysplastic change in the myeloid series (panel B; Perl’s stain).

A 63-year-old man presented with symptoms of anemia. The only other symptom of note was some change in personality with unusually aggressive behavior. His blood count was as follows: hemoglobin 65 g/L, white blood cell count 6.5 × 109/L (normal differential count), and platelet count 509 × 109/L. The blood film (panel A) was leukoerythroblastic with target cells and marked basophilic stippling. Liver function test results and hematinics were normal.
On retaking the clinical history, it was noted that he was a painter and had been working on an old house for several months, removing paint. His blood lead level was 4.9 μmL/L (reference range without exposure to industrial lead is 0-0.48 μmL/L) with a high 24-hour urinary lead level of 2130 nmol (normal range, 0-100). These results were consistent with severe lead poisoning. He was treated with chelation with intravenous sodium calcium edetate, intravenous fluids, and zinc supplementation. He obtained gradual improvement in psychiatric symptoms and normalization of blood count. He did not have the usual classical symptoms of lead poisoning. His bone marrow aspirate and trephine morphology showed marked dyserythropoiesis with sideroblastic change and also less marked dysplastic change in the myeloid series (panel B; Perl’s stain).
A 63-year-old man presented with symptoms of anemia. The only other symptom of note was some change in personality with unusually aggressive behavior. His blood count was as follows: hemoglobin 65 g/L, white blood cell count 6.5 × 109/L (normal differential count), and platelet count 509 × 109/L. The blood film (panel A) was leukoerythroblastic with target cells and marked basophilic stippling. Liver function test results and hematinics were normal.
On retaking the clinical history, it was noted that he was a painter and had been working on an old house for several months, removing paint. His blood lead level was 4.9 μmL/L (reference range without exposure to industrial lead is 0-0.48 μmL/L) with a high 24-hour urinary lead level of 2130 nmol (normal range, 0-100). These results were consistent with severe lead poisoning. He was treated with chelation with intravenous sodium calcium edetate, intravenous fluids, and zinc supplementation. He obtained gradual improvement in psychiatric symptoms and normalization of blood count. He did not have the usual classical symptoms of lead poisoning. His bone marrow aspirate and trephine morphology showed marked dyserythropoiesis with sideroblastic change and also less marked dysplastic change in the myeloid series (panel B; Perl’s stain).
For additional images, visit the ASH IMAGE BANK, a reference and teaching tool that is continually updated with new atlas and case study images. For more information visit http://imagebank.hematology.org.